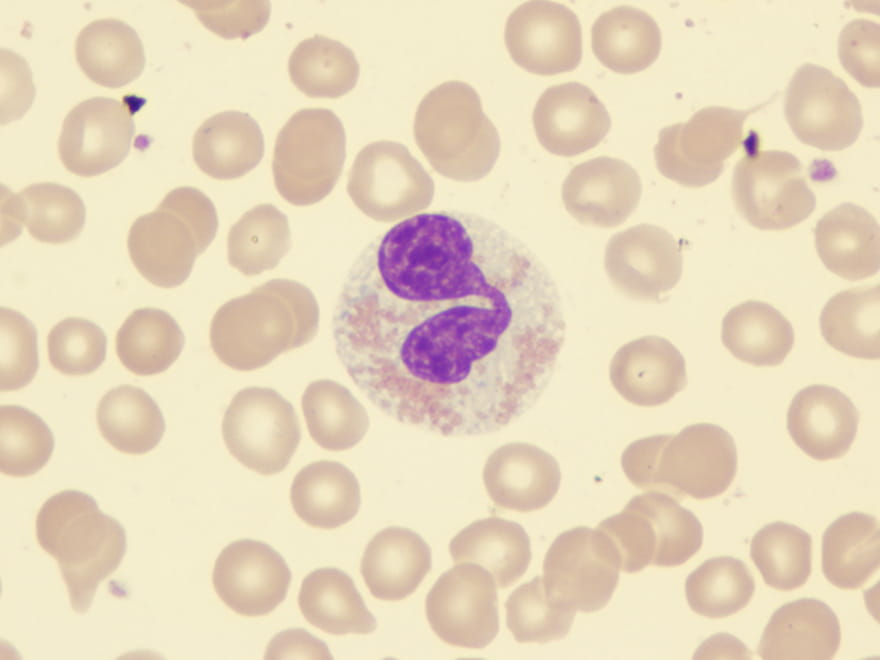
Miyelodisplastik Sendrom

Halk arasında çok fazla bilinmeyen ama oldukça önemli bir kan hastalığı olan Miyelodisplastik Sendrom, yani kısaca MDS.
Miyelodisplastik Sendrom (MDS) Nedir?
Miyelodisplastik Sendrom kemik iliğinde kan hücrelerinin üretiminde sorun oluşmasıyla ortaya çıkan bir grup hastalığın genel adıdır.
Normalde kemik iliğimiz, kırmızı kan hücreleri, beyaz kan hücreleri ve trombositleri üretmektedir. Ancak MDS’de bu hücrelerin üretimi bozulur ve genellikle bu hücreler tam olgunlaşmadan kana geçer ya da hiç geçemezler.
Miyelodisplastik Sendrom (MDS) Kimlerde Görüşür?
Genellikle 60 yaş üzerindeki bireylerde görülmektedir. Ancak daha genç yaşlarda da nadiren görülebilir. Geçmişte kemoterapi veya radyoterapi almış kişilerde, bazı çevresel toksinlere (örneğin benzen) maruz kalanlarda da MDS riski artabilmektedir.
Miyelodisplastik Sendrom (MDS) Belirtileri
MDS sinsi ilerleyebilen bir hastalıktır. Belirtiler genellikle kansızlık ve bağışıklık sistemiyle ilgili sorunlara bağlı olarak ortaya çıkmaktadır:
- Halsizlik, Yorgunluk
- Solukluk
- Enfeksiyonlara Yatkınlık
- Kolay Morarma veya Kanama
- Nefes Darlığı
Miyelodisplastik Sendrom (MDS) Tanısı
Tanı koymak için kan testleri ve kemik iliği biyopsisi yapılır. Bu sayede kemik iliğindeki hücrelerin sayısı ve yapısı incelenir. Ayrıca genetik testlerle hücrelerdeki kromozom bozuklukları da değerlendirilir.
MDS Tehlikeli Bir Hastalık Mıdır?
MDS hafif seyreden bir hastalık olabileceği gibi, bazı vakalarda zamanla kötüleşerek Akut Miyeloid Lösemi'ye (AML) dönüşebilir. Bu nedenle takip çok önemlidir. Risk grubu belirlenerek her hastaya özel tedavi planı yapılır.
MDS Hastalığında Tedavi Seçenekleri Nelerdir?
Tedavi, hastalığın risk derecesine ve hastanın genel durumuna göre planlanır:
- Destek Tedavileri: Kan transfüzyonları, büyüme faktörleri.
- İlaç Tedavileri: Hipometile edici ajanlar (örneğin azasitidin).
- Kemik İliği Nakli: Uygun hastalarda kür sağlayabilen tek yöntemdir, genellikle genç ve uygun donör bulunan hastalarda düşünülür.
Takip ve Yaşam Kalitesi
MDS, düzenli takip gerektiren bir hastalıktır. Belirtiler ve kan değerleri zamanla değişebilir. Bu nedenle belli aralıklarla kontroller önemlidir. Beslenme, enfeksiyonlardan korunma ve psikolojik destek, yaşam kalitesini artırmada önemli rol oynar.
Unutmayın, MDS her hastada farklı seyreder. Erken tanı, düzenli takip ve kişiye özel tedavi ile yaşam süresi ve kalitesi artırılabilmektedir.
Güncellenme Tarihi: 02 Mart 2026 Pazartesi







